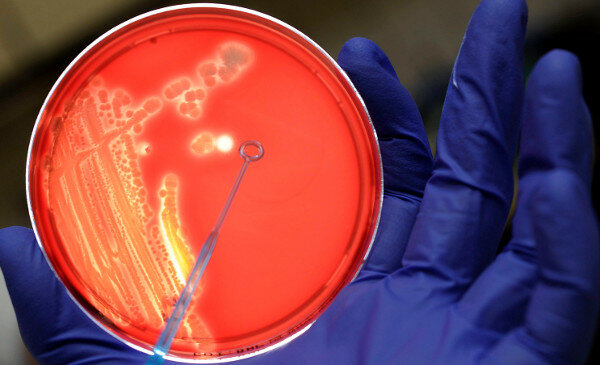
Existencias palmarias patológicas

-
Contribución en los hospitales mentales a las personas para que reciban un tratamiento más digno y humano.
-
Progreso en la comprensión y los trastornos mentales
-
Consideraba al igual que Hipócrates que los trastornos mentales se generaba a raíz de un desequilibrio de humores
-
Padre de la medicina moderna.
Consideraba que el cerebro era el órgano principal de la actividad intelectual y que los trastornos mentales se debían a una patología del mismo. -
Estudio como tratar a las personas con trastornos mentales con historial criminal
-
Descripción de la confirma y de los problemas mentales
Factores psicológicos como frustración y conflicto -
Anatomía del sistema nervioso, adopta una perspectiva científica dividiendo las causas de los trastornos psicológicos
-
Propuso dos aspectos como causa de estos trastornos; lo físico y lo mental
-
Inicio de un tratamiento adecuado y adaptado para los pacientes con trastornos mentales
-
 Albrecht von Haller basa su idea en que os trastornos mentales están ligados con el funcionamiento cerebral y para este análisis se debía hacer disecciones post-mortem en personas que padecían algún tipo de trastorno mental para así hacer comparación de las distintas disecciones elaboradas. (Butcher, Mineka, & Hooley, 2007)
Albrecht von Haller basa su idea en que os trastornos mentales están ligados con el funcionamiento cerebral y para este análisis se debía hacer disecciones post-mortem en personas que padecían algún tipo de trastorno mental para así hacer comparación de las distintas disecciones elaboradas. (Butcher, Mineka, & Hooley, 2007) -
 Mesmer trató a las personas mediante distintos fluidos, ya que mencionaba que cada sujeto tenía su fluido y cada fluido afectaba a los demás, siendo una posible hipnosis o manipulación mental para tratar distintos trastornos mentales
Mesmer trató a las personas mediante distintos fluidos, ya que mencionaba que cada sujeto tenía su fluido y cada fluido afectaba a los demás, siendo una posible hipnosis o manipulación mental para tratar distintos trastornos mentales -
 Creó un lugar adaptado a las necesidades de pacientes patológicos llamado el Retiro de York
Creó un lugar adaptado a las necesidades de pacientes patológicos llamado el Retiro de York -
 Fundó la psiquiatría en América, con principios humanitarios de Pinel
Fundó la psiquiatría en América, con principios humanitarios de Pinel -
 A. Bayle clasificó a la paresia general como un trastorno mental
A. Bayle clasificó a la paresia general como un trastorno mental -
 Wilhelm Griesinger determinó que los trastornos mentales estaban netamente ligados con patologías o alteraciones cerebrales
Wilhelm Griesinger determinó que los trastornos mentales estaban netamente ligados con patologías o alteraciones cerebrales -
 Wilhem Wundt crea el primer laboratorio de psicología experimental
Wilhem Wundt crea el primer laboratorio de psicología experimental -
 En busca de realizar un estudio empírico de la conducta patológica crea el primer laboratorio experimental
En busca de realizar un estudio empírico de la conducta patológica crea el primer laboratorio experimental -
 Funda el psicoanálisis
Funda el psicoanálisis -
 Witmer se centró en los niños con deficiencia mental, tanto desde un punto de vista clínico como investigador. Considerado el fundador de la psicología clínica
Witmer se centró en los niños con deficiencia mental, tanto desde un punto de vista clínico como investigador. Considerado el fundador de la psicología clínica -
 "von Wassermann desarrolló un
"von Wassermann desarrolló un
análisis de sangre que permitía detectar la sífilis" (Butcher, Mineka, y Hooley, 2007) -
 Instituto de Investigación Juvenil
Instituto de Investigación Juvenil
Creado por William Healy, se crea con la finalidad de analizar o describir las distintas patologías encontradas en los adolescentes de Chicago -
 Descubren que la fenotiazina reducía los síntomas psicóticos y comenzaron a utilizarla en pacientes psiquiátricos.
Descubren que la fenotiazina reducía los síntomas psicóticos y comenzaron a utilizarla en pacientes psiquiátricos. -
 El senador Thomas Eagleton fue sometido a una terapia electro convulsiva, derivada de un tratamiento para su depresión, generando que en la sociedad esté fuera visto como un demente, porque consecuente tuvo que abandonar su cargo gracias a los estereotipos creados.
El senador Thomas Eagleton fue sometido a una terapia electro convulsiva, derivada de un tratamiento para su depresión, generando que en la sociedad esté fuera visto como un demente, porque consecuente tuvo que abandonar su cargo gracias a los estereotipos creados. -
 Kirk y Kutchins, establecen que el rango de problemas al cual se enfrenta el profesional en salud mental parte de una perspectiva puramente pragmática, delimitada por el tipo de enfermedades que puede padecer una sociedad
Kirk y Kutchins, establecen que el rango de problemas al cual se enfrenta el profesional en salud mental parte de una perspectiva puramente pragmática, delimitada por el tipo de enfermedades que puede padecer una sociedad -
 Señaló uno de los primeros paradigmas para explicar la personalidad o el temperamento
Señaló uno de los primeros paradigmas para explicar la personalidad o el temperamento -
 Blashfield y Livesley, mencionan algunas consecuencias derivadas de una clasificación de trastornos mentales que pueden llegar a influir al sujeto de manera social y política.
Blashfield y Livesley, mencionan algunas consecuencias derivadas de una clasificación de trastornos mentales que pueden llegar a influir al sujeto de manera social y política. -
 Sptizer Indica que en los casos se carece de una definían propia en los trastornos, sin embargo se tienen claras las conductas patologías y cuáles no.
Sptizer Indica que en los casos se carece de una definían propia en los trastornos, sin embargo se tienen claras las conductas patologías y cuáles no. -
 Se genera una reedición del DSM-4, siendo renombrado como DSM-4 TR, donde se actualizan los datos de las distintas patologías.
Se genera una reedición del DSM-4, siendo renombrado como DSM-4 TR, donde se actualizan los datos de las distintas patologías. -
Patiño Seligman propone que una respuesta aclaratoria radica en los hechos de la existencia de aspectos palmarios dentro de la misma patología.
Patiño Seligman propone que una respuesta aclaratoria radica en los hechos de la existencia de aspectos palmarios dentro de la misma patología.